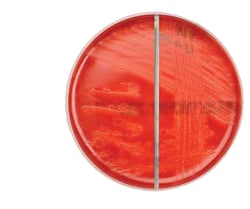
Thermo Scientific A.R.I.A. Medium with 5% Horse Blood/A.R.I.A. Medium with 5% Horse Blood and Neomycin Biplate | Buy Online | Thermo Scientific&trade; | Fisher Scientific

Learn More
Thermo Scientific™ A.R.I.A. Medium with 5% Horse Blood/A.R.I.A. Medium with 5% Horse Blood and Neomycin Biplate
Description
Cultivate anaerobic bacteria within 24 -72 hours while simultaneously isolating the anaerobic bacteria with Thermo Scientific™ Oxoid™ A.R.I.A. Medium with 5% Horse Blood/A.R.I.A. Medium with 5% Horse Blood and Neomycin Biplate.
The A.R.I.A. Medium with 5% Horse Blood is a non-selective growth medium for anaerobic bacteria while A.R.I.A. Medium with 5% Horse Blood and Neomycin is a selective medium to help isolate anaerobic bacteria. The convenient bi-plate format frees up incubator space and reduces the materials used to create an anaerobic environment reducing costs and waste.
Read more results from a single patient sample and produce more diagnostic details of pathogenic organisms while reducing storage capacity issues in the incubator with a bi-plate that includes a selective and non-selective media on a single plate.
- Allows isolation and accurate species determination of anaerobic bacteria from clinical samples within 24- 72 hours.
- Ready-to-use convenience of prepared media
- Space-saving biplate format
- Save material cost to create anaerobic atmosphere with the biplate format
Anaerobic bacteria are known to cause a wide variety of human infections of the skin and soft tissues, and of the respiratory, gastrointestinal and female genital tracts. The need to determine the presence of anaerobes from clinical samples has become increasingly important with the re-emergence of anaerobic bacteremia and the prevalence of multiple-drug-resistant microorganisms.
Culture is a common method of diagnosing anaerobic infections, and it is important for the microbiology laboratory to be able to easily determine colonial and cellular morphology of anaerobic species. The type of agar used can have a significant effect on these characteristics. A.R.I.A. medium is designed to isolate and allow accurate species determination of anaerobic bacteria from clinical samples within 24-72 hr.
Not all products are available for sale in all territories. Please inquire.
Remel™ and Oxoid™ products are now part of the Thermo Scientific brand

Specifications
Specifications
| Color | Carmine red, opaque |
| Content And Storage | 2°C to 8°C |
| Description | A.R.I.A. Medium with 5% Horse Blood/ A.R.I.A. Medium with 5% Horse Blood and NeomycinBiplate |
| Format | Biplate |
| Manufacturing Origin | United Kingdom |
| Product Type | Microbiology Media |
| Fill Weight | 17g ± 5 % |
| Packaging Type | Flow Wrapped - Single Layer |
| Quantity | 10 Pack |
Your input is important to us. Please complete this form to provide feedback related to the content on this product.